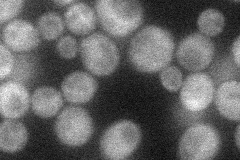
YOL036W
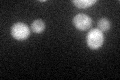
YOL036W

View description
Protein of unknown function; potential Cdc28p substrate
Localization:
Intensity:
Fold change:
Significance:
-
C’ GFP library in SD

cytosol22.12 -
N' NOP1pr-GFP in SD
cytosol,punctate34.5852 -
N' TEF2pr-mCherry in SD

below threshold9.82138 -
N' NATIVEpr-GFP in SD

ambiguous21.4449 -
N' TEF2pr-VC and Cyto-VN in SD

below threshold27.2031 -
C’ GFP library in SD+DTT
cytosol20.890.94No -
C’ GFP library in SD+H2O2

cytosol21.650.97No -
C’ GFP library in Starvation Media

cytosol17.970.81No -
C’ GFP library on the background of Pup2-DaMP

cytosol -
C’ GFP library on the background of CCT mutant

cytosol23.15421.04631No
